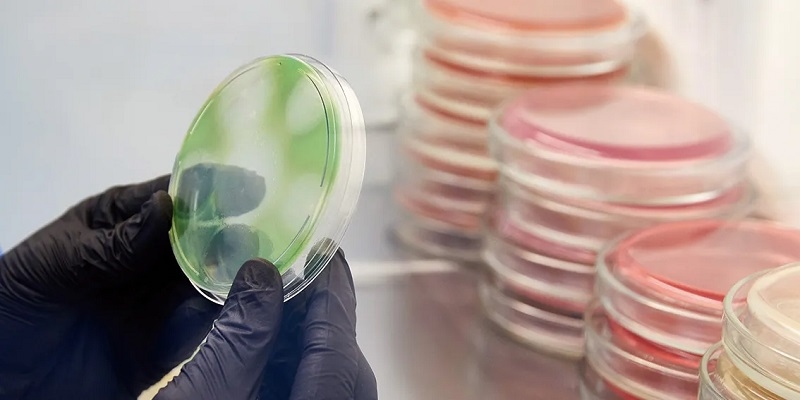

RAYPA培養(yǎng)基自動制備分裝儀
RAYPA公司AE-MP 系列標(biāo)準(zhǔn)培養(yǎng)基制備器 經(jīng)典系列
自動培養(yǎng)基制備器
自動、安全、高效的培養(yǎng)基制備解決方案。
自動制備和快速分配
節(jié)省成本、減少制備時間并減少工作量
靈活性和可擴(kuò)展性:6 種型號和 4 種分配模式

簡介
AE-MP系列培養(yǎng)基制備器通過節(jié)省成本、制備時間和工作量,優(yōu)化了微生物學(xué)和植物組織實(shí)驗(yàn)室的
工作流程。
單個設(shè)備涵蓋了高質(zhì)量培養(yǎng)基的制備、消毒、快速冷卻和分配,具有出色的批次間再現(xiàn)性。其設(shè)計
防止了污染、膠化、溶解性或均勻性問題,以及燒傷。
AE-MP系列培養(yǎng)基制備器旨在減少總的培養(yǎng)基制備時間并能制備大量的培養(yǎng)基。根據(jù)6種培養(yǎng)基制備器
尺寸和4種可用的分配模式中,選擇最適合您實(shí)驗(yàn)室的配置。此外,每個型號的加熱能力都可以升級,
以大幅減少加熱階段的持續(xù)時間。

簡化您的準(zhǔn)備時間,加快分配速度,減少工作量
與傳統(tǒng)的高壓蒸汽滅菌器制培養(yǎng)基相比,可以享受更快的生產(chǎn)時間。制備體積范圍為2L至90L,分配速度范圍
為7mL/s至100mL/s。還可以選擇最符合您要求的培養(yǎng)基分裝溫度。
無需費(fèi)力的清潔,具有多種自動化功能
在分裝階段之前、分裝期間以及分裝之后,可以使用蒸汽脈沖對分裝管路進(jìn)行清潔和消毒,以防止污染。您可以在分裝期間進(jìn)行暫停,也可以避免瓊脂凝固的問題。內(nèi)部不銹鋼容器具有符合人體工程學(xué)的手柄,可以很容易地拆卸與移開。

專業(yè)滅菌,重現(xiàn)性極佳
使用柔性探頭和F? 調(diào)節(jié)可以以最大的精度進(jìn)行滅菌。能夠配置帶有斜坡的程序來準(zhǔn)備特殊的培養(yǎng)基配方。盡量減少對污染、沉淀、均勻性或過度加熱的擔(dān)憂。記錄并分析每批次的處理情況。
操作
A.加熱階段
滅菌室的強(qiáng)大加熱元件將水加熱以產(chǎn)生飽和蒸汽,并加熱位于內(nèi)部容器內(nèi)中的培養(yǎng)基。同時,可調(diào)速度的磁力攪拌器,確保溶質(zhì)在溶劑中充分的溶解。
應(yīng)用
瓊脂的制備
快速冷卻系統(tǒng)節(jié)省了大量時間。此外,由于溫度可以無限期地保持在所選溫度,因此您可以隨時開始分配已滅菌的培養(yǎng)基。同樣,由于壓力支持系統(tǒng),分裝過程可以中斷并在稍后再恢復(fù)分裝,以防止分裝管路內(nèi)的瓊脂凝固。
植物組織培養(yǎng)
由于通過壓力支持進(jìn)行分配,您可以在高速下分配大量液體。此外,容積更大的型號可以更大功率加熱,加上快速冷卻,可以大大減少每個循環(huán)的持續(xù)時間??梢允褂猛獠糠盅b端口隨時分配pH調(diào)節(jié)劑。

緩沖溶液的制備
由于通過壓力支持進(jìn)行分配,您可以高速分配大量液體。此外,較大的型號可以超負(fù)荷,這加上快速冷卻,可以大大減少每個循環(huán)的持續(xù)時間。可以使用外部的分裝端口隨時分配pH調(diào)節(jié)劑。

LB培養(yǎng)基(LYSOGENY BROTH)的制備
由于通過壓力支持進(jìn)行分配,因此可以高速分配大體積。此外,容積更大的型號可以更大功率加熱,加上快速冷卻,可以大大減少每個循環(huán)的持續(xù)時間。

技術(shù)參數(shù)
![]() | ![]() | ![]() | ![]() | ![]() | ![]() | |
| 型號 | AE-20-MP-10L | AE-20-MP | AE-40-MP | AE-60-MP | AE-80-MP | AE-100-MP |
|
制備培養(yǎng)基的最大容量 L | 8 | 18 | 36 | 54 | 72 | 90 |
|
制備培養(yǎng)基的最小容量*(按F0或按時間) L | 2或5 | 2或10 | 5或20 | 10或30 | 20或50 | 20或70 |
外部尺寸L×D×H mm | 689×815×735 | 689×815×735 | 615×815×1100 | 615×815×1320 | 755×935×1285 | 755×935×1385 |
內(nèi)部尺寸?×H mm | 210×236 | 330×236 | 330×461 | 330×696 | 420×594 | 420×734 |
| 凈重 kg | 125 | 128 | 135 | 155 | 244 | 265 |
| 功率kW | 3 | 3 | 6或12 | 9或15 | 15,20或30 | 15,20或30 |
| 電壓 V | 230 | 230 | 400 | 400 | 400 | 400 |
| 頻率 Hz | 50/60 | 50/60 | 50/60 | 50/60 | 50/60 | 50/60 |
視頻
資訊中心
- 公司成為日本ICOMES公司電動移液器pipetty產(chǎn)品中國區(qū)總代理 2020-10-09
- RAYPA公司攜頂尖的培養(yǎng)基自動制備儀器亮相2026 analytica 2026-04-08
- 廣州程淇生物公司在第二屆海南食品安全檢測技術(shù)研討會的精彩回顧 2025-11-12
- Pipetty電動移液器在基孔肯雅病毒核酸檢測(實(shí)時熒光-PCR)中的應(yīng)用 2025-07-18
- ICOMES公司參加第 30 屆 Machine Element Technology Expo 2025-07-09
- RAYPA自動培養(yǎng)基制備器在植物組織培養(yǎng)中的應(yīng)用方案 2025-04-21
- 案例研究:歐陸科技(Eurofins Scientific)食品微生物實(shí)驗(yàn)室使用培養(yǎng)基制備器制備蛋白胨水 2025-04-17
- 250μL 量程pipetty電動移液器高精度連續(xù)分液并可提高分液效率 2024-11-12













